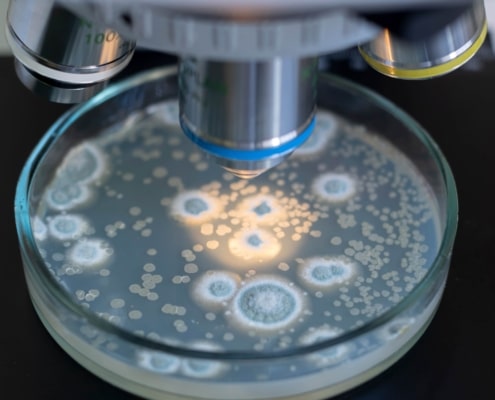
climate change bacteria's gain

Climate change: Best conditions for resistance
Climate change is stressing plants, animals and humans. But there are also beneficiaries – including many bacteria. Most thrive particularly well at temperatures above 30 degrees Celsius. So are some specimens of particular concern: antibiotic-resistant germs. The good news is that there are things you can do to protect yourself and others from them.
Climate change exacerbates the problem
With the discovery of antibiotics, infectious diseases from plague to syphilis have lost their terror. However, due to the mass use of drugs, more and more germ variants are formed that cannot be harmed by the usual antibiotics.
The WHO now ranks antibiotic resistance among the top ten major human health threats. And climate change is already exacerbating the problem.
High temperatures, more antibiotics
“Studies show that at higher temperatures, more antibiotics are prescribed,” says Dr. Sebastian Haller, infection epidemiologist at the Robert Koch Institute (RKI) in conversation with NetDoktor.
The human immune system has greater difficulty in keeping a bacterial infection in check due to the heat-induced bacterial growth. It then needs the protection of antibiotic drugs all the more. The problem: the more antibiotics are prescribed, the more resistant germs gain ground.
Heat promotes bacterial gene exchange
But this connection is not the only driver of resistance: “There are indications that bacteria also exchange their genes more frequently at higher temperatures – including those responsible for resistance,” says Haller, who is working on the current comprehensive report with his working group of the RKI on the health effects of climate change.
According to the RKI, around 670,000 people in the EU contract infections caused by antibiotic-resistant pathogens every year – around 33,000 people die from it. “So far, these infections can still be treated because there are reserve antibiotics,” says the infection epidemiologist. “But we’re worried that at some point they won’t work anymore either.”
The hospital as a hotbed
Most infections with resistant pathogens take place precisely where people hope to recover: in hospitals. The germs often get into the clinics on the skin of patients. Thanks to a well-functioning immune system, they can usually not harm the wearers themselves. However, if there is no meticulous hygiene, the germs can be transmitted to other patients with weaker immune systems or those who have just had surgery. That can be dangerous.
Methicillin-resistant Staphylococcus aureus, MRSA for short, is notorious. It is not only resistant to methicillin, but often also to various other important antibiotics.
In hot months, the germs multiply rapidly thanks to the often unair-conditioned hospital rooms, especially in fresh surgical wounds – or after the patients have been discharged at home in overheated apartments. Such infections are difficult to treat and can progress to life-threatening sepsis (“blood poisoning”).
Use antibiotics wisely and to a limited extent
“In view of the changed conditions caused by climate change, it is all the more important that we keep the number of resistances low overall,” says Haller. The central measure for this is: only use antibiotics when it makes sense – and only then.
However, many patients also want antibiotic therapy for viral infections – against which the drugs cannot work at all. According to a Forsa survey from 2018, 72 percent of those suffering from a cold hope for a prescription if their symptoms don’t subside quickly enough.
In one in ten cases, the doctors then gave in to the urge in 2021 – apparently against their better judgment. However, a positive trend is emerging here: in 2010, unnecessary administration of antibiotics for colds was four times as common.
Transmission of resistance genes in the gut
“The more people take antibiotics, the more often resistance develops,” explains Haller. “When we swallow an antibiotic, we treat all the other bacteria in the body as well.” It is often harmless intestinal bacteria that initially become resistant to an antibiotic.
With the next infection, they pass on their genetic protective mechanism against antibiotics to the dangerous guest in the intestine. And then the body suddenly has to deal with an opponent who is immune to antibiotics.
It is therefore also in your own interest not to have any unnecessary antibiotic treatments carried out: otherwise the risk of breeding resistance in your own intestine increases.
Less meat, less resistances
Another way to reduce the spread of resistant germs seems surprising at first: eat less meat. The reason: antibiotics are used on a large scale, at least in factory farming. Because in the cramped stalls, diseases otherwise spread like wildfire.
“If you have a sick animal, the whole barn is often given medication,” reports Haller. According to a report by the Federal Institute for Risk Assessment, around 80 percent of poultry from large-scale farms come into contact with antibiotics in this way. Even organic meat is not free of medicines.
After all, there is movement in the market. In the USA, the first providers are presenting “antibiotic-free chicken”, and pioneers are also at the start in Europe, reports Haller: “In Italy they are already advertising Parma ham that is free of antibiotics.”
Those who are vaccinated do not need antibiotics
Another big lever that individuals can use to help limit antibiotic use is to get vaccinated. The first priority is the pneumococcal vaccination as protection against bacterial pneumonia. Experts recommend them, among others, to people over the age of 60 and chronically ill people such as those with lungs, heart disease and diabetes. If you don’t catch pneumonia in the first place, you don’t need antibiotic therapy afterwards, according to the simple equation.
The same goes for the flu shot. It is aimed at viruses and not bacteria. Bacterial pneumonia quickly sets in, especially when the immune system is weaker due to age or illness. “You can see that where there is a lot of vaccination, the use of antibiotics is reduced,” says Haller.
“We need to change our behaviour”
It is a collective societal effort to counteract climate change – and also the increasing resistance to antibiotics. “In order to meet the new circumstances, we all have to change our behaviour,” said the infectiologist. Bacteria are masters of adaptation. It is high time that people learned something new in this regard.
The United Arab Emirates (UAE), known for its traditionally dry and arid climate, has witnessed a remarkable transformation in recent years due to rapid urbanization and population growth. While the desert environment was historically inhospitable to bacteria and germs, the modern infrastructure, increased human activity, and densely populated urban areas have created new challenges. The construction boom, expansion of transportation networks, and the establishment of large-scale commercial and residential developments have altered the ecological balance. These changes, coupled with a surge in population, have led to increased waste generation, inadequate sanitation systems, and overcrowding in certain areas. Consequently, the UAE is facing new public health concerns, such as the spread of communicable diseases and the proliferation of bacteria and germs. To address these challenges, the UAE government has implemented rigorous hygiene and sanitation regulations, invested in advanced waste management systems, and focused on public health awareness campaigns to mitigate the potential risks associated with urbanization and rapid population growth.